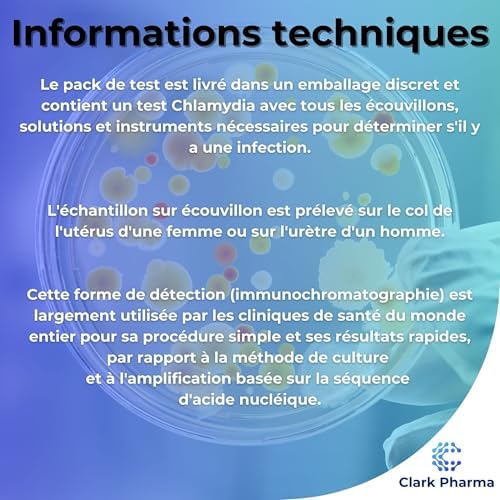

Test Chlamydia Rapide Fiable - Guide Expert Test de Dépistage
Par l'équipe Kit-Depistage - Experts en Santé
Pourquoi nous recommandons Test Chlamydia Rapide Fiable
Notre équipe d'experts Kit-Depistage a analysé Test Chlamydia Rapide Fiable dans notre guide des meilleurs ist infections sexuelles 2026. Cette analyse s'appuie sur l'évaluation de la fiabilité, de la certification CE, de la facilité d'utilisation et de la précision des résultats pour vous guider dans le choix optimal de votre test de dépistage selon vos besoins de santé.
Caractéristiques du test de dépistage
- Évaluation experte : 5 sur 5 étoiles
- Catégorie santé : IST Infections Sexuelles
- Disponibilité : Test disponible - Certifié CE
- Gamme de prix observée : 10,00 €
- Type : Test de dépistage médical
Notre guide IST Infections Sexuelles
Produits de ist infections sexuelles
Dans cette section dédiée aux tests de dépistage, nous vous présentons notre analyse des meilleurs ist infections sexuelles pour votre santé et votre prévention. Chaque test est évalué selon des critères médicaux stricts : certification CE, fiabilité des résultats, facilité d'utilisation et précision clinique pour vous accompagner dans votre diagnostic et prévention santé.
Méthodologie d'évaluation
Notre équipe analyse les ist infections sexuelles selon plusieurs critères professionnels : certification dispositif médical, fiabilité des résultats, facilité d'utilisation, rapidité du diagnostic, conformité aux normes européennes et précision clinique. Test Chlamydia Rapide Fiable répond à nos standards d'exigence pour constituer un choix fiable pour votre santé et dépistage préventif.
Guide d'utilisation et conseils
Avant d'utiliser Test Chlamydia Rapide Fiable, consultez notre guide complet qui détaille le mode d'emploi, les conditions de prélèvement, l'interprétation des résultats et les précautions d'usage. Nous vous aidons à évaluer si ce test correspond à votre situation, vos besoins de dépistage et vos objectifs de santé pour optimiser votre diagnostic préventif.
Indications et précautions
Test Chlamydia Rapide Fiable est un test de dépistage médical. Son utilisation doit être adaptée à votre situation de santé. En cas de doute sur les résultats ou de symptômes persistants, consultez votre médecin ou professionnel de santé. Respectez les recommandations du fabricant concernant les conditions de stockage et d'utilisation pour garantir la fiabilité des résultats du test.